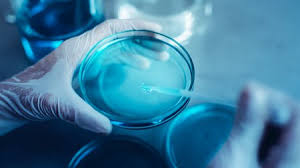

Häufig gestellte Fragen
Durch diese FAQs bieten wir unseren Kunden einen Überblick und unterstützende Informationen, um ihr Einkaufserlebnis zu verbessern und Vertrauen in unsere Produkte zu fördern.
Unsere Produkte enthalten wichtige fettlösliche Vitamine und sollten deshalb idealerweise mit einer Mahlzeit eingenommen werden, um eine optimale Absorption zu gewährleisten.
Ja, jedem Produkt liegt eine detaillierte Auflöseanleitung bei, um die korrekte Zubereitung zu gewährleisten.
Da Nahrungsergänzungsmittel keine Arzneimittel sind, dürfen wir keine spezifischen Aussagen über gesundheitsförderliche Effekte machen. Für individuelle Beratung empfehlen wir die Konsultation eines Therapeuten.
Unsere Produkte werden in Zusammenarbeit mit medizinischen und ernährungswissenschaftlichen Experten entwickelt, um sicherzustellen, dass sie die wesentlichen Mikronährstoffe enthalten, die zur Unterstützung der Gesunderhaltung und bei bestimmten Erkrankungen benötigt werden. Für eine individuelle Bedarfsanalyse ist eine Mikronährstoffanalyse durch einen erfahrenen Therapeuten empfehlenswert.
Unsere Produkte sind für eine regelmäßige und langfristige Einnahme konzipiert. Beachten Sie die empfohlene Dauer auf der Verpackung und geben Sie dem Produkt Zeit, seine Wirkung zu entfalten.
Die Haltbarkeit variiert je nach Produkt. Überprüfen Sie das Ablaufdatum auf der Verpackung und bewahren Sie das Produkt entsprechend der Anweisungen auf, um die Qualität zu erhalten.
Bitte konsultieren Sie vor der Einnahme unserer Produkte während der Schwangerschaft oder Stillzeit einen Arzt oder Therapeuten.
Bitte überprüfen Sie die Produktbeschreibung und die Zutatenlisten, um sicherzustellen, dass das Produkt Ihren Ernährungsbedürfnissen entspricht.
Wir empfehlen, vor der Kombination unserer Produkte mit anderen Medikamenten Rücksprache mit einem Arzt oder Therapeuten zu halten.
Ja, unser Kundenservice-Team steht Ihnen für alle weiteren Fragen zur Verfügung. Sie können uns per E-Mail, Telefon oder über unser Kontaktformular auf der Webseite erreichen.
Alles für Ihre Gesundheit
Gute Inhaltsstoffe sind essenziell für Ihre Gesundheit. Unsere Produkte werden mit Experten sorgfältig entwickelt, um Ihr Wohlbefinden wie ein präzises Uhrwerk zu unterstützen. Selbst eine kleine Veränderung kann einen spürbaren Unterschied bewirken.
Unsere Produkte sind empfohlen von Therapeuten, darunter Ärzte für Naturheilkunde, Orthopäden, Kardiologen, Gynäkologen, Nephrologen und Heilpraktiker.
Patentiertes Vitamin K2
Leider kann man stabilitäts- produktionsbedingt nicht immer vollständig auf Hilfsstoffe verzeichten.
Vitamin K2 wird in unseren Produkten durch eine hauchzarte Zuckermolekülschicht geschützt, um seine empfindliche Struktur vor schädlichen Elementen in Kapseln und Pulvern zu bewahren.
Das führt zu mehr Stabilität, längerer Haltbarkeit, verbesserter Thermobeständigkeit und Bioverfügbarkeit von Vitamin K2 in unseren Produkten.
Hergestellt aus Rosen- und Geranienblättern
Der Ursprung ist die Natur. Unser Vitamin K2 MK-7 wird aus Blütenblättern fermentativ gewonnen, schonend extrahiert und kristallisiert, um 100% biologisch aktive Form zu erreichen, im Gegensatz zu Natto-basierten Prozessen, die bis zu 30% inaktive cis-Isomere produzieren.
Unsere Produkte enthalten nur natürliche Inhaltsstoffe, was ihre ausgezeichnete Verträglichkeit erklärt.
Kein Plastik
Unsere Vitamin K2-Produkte sind in Alusticks und Braunglasflaschen verpackt, um sie optimal vor Licht zu schützen. Transparente Plastikflaschen verwenden wir nicht, da sie den Schutz nicht gewährleisten.
Verbesserter Lichtschutz für mehr Stabilität und Haltbarkeit. Unsere Produkte enthalten genau das, was angegeben ist, mit einem hohen Vitamin K2-Gehalt.